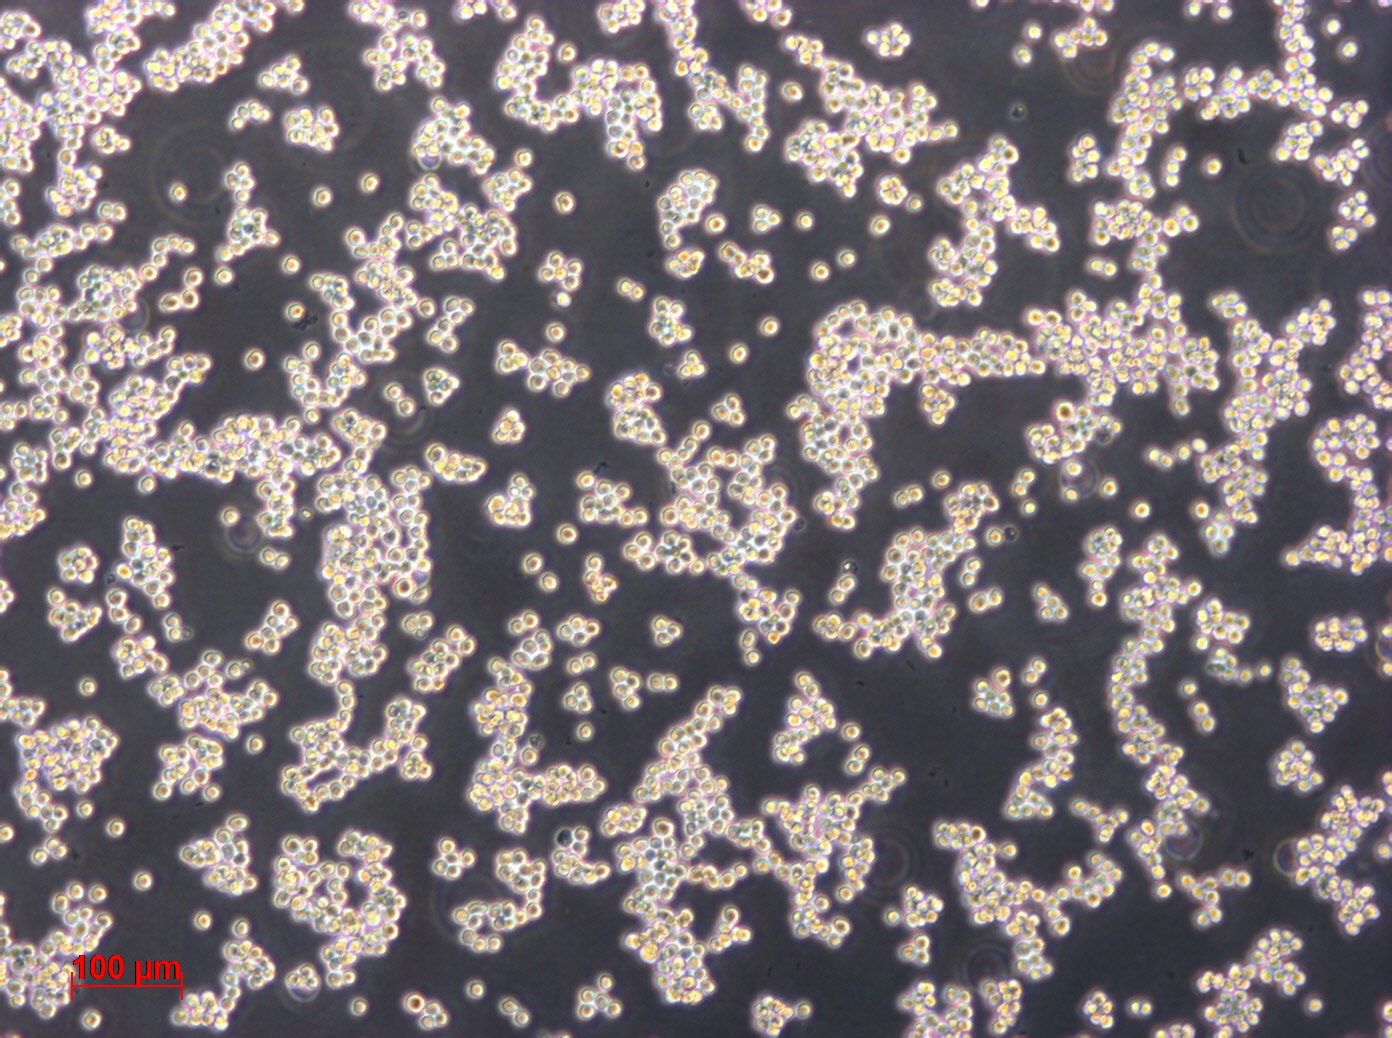
L5178Y细胞图片

L5178Y TK+/- (clone 3.7.2C)细胞ATCC CRL-9518小鼠淋巴瘤细胞特点和简介
这株细胞是L5178Y TK+/- (clone 3.7.2C)-S的衍生株。 在本库通过支原体检测。L5178Y TK+/- (clone 3.7.2C)细胞ATCC CRL-9518小鼠淋巴瘤细胞接受后处理
1) 收到细胞后,请检查是否漏液 ,如果漏液,请拍照片发给我们。2) 请先在显微镜下确认细胞生长 状态,去掉封口膜并将T25瓶置于37℃培养约2-3h。
3) 弃去T25瓶中的培养基,添加 6ml本公司附带的完全培养基。
4) 如果细胞密度达80%-90%请及 时进行细胞传代,传代培养用6ml本公司附带的完全培养 基。
5) 接到细胞次日,请检查细胞是 否污染,若发现污染或疑似污染,请及时与我们取得联 系。
L5178Y TK+/- (clone 3.7.2C)细胞ATCC CRL-9518小鼠淋巴瘤细胞培养操作
1)复苏细胞:将含有 1mL 细胞悬液的冻存管在 37℃水浴中迅速摇晃解冻,加 入 4mL 培养基混合均 匀。在 1000RPM 条件下离心 4 分钟,弃去上清液,补 加 1-2mL 培养基后吹匀。然 后将所有细胞悬液加入培养瓶中培 养过夜(或将 细胞悬液加入 10cm 皿中,加入约 8ml 培养基,培养 过夜)。第二天换液并 检查细胞密度。2)细胞传代:如果细胞密度达 80%-90%,即可进行传代培养。 1. 弃去培养上清,用不含钙、镁离子的 PBS 润洗细胞 1-2 次。
2. 加 1ml 消化液(0.25%Trypsin-0.53mM EDTA)于培养瓶 中,置于 37℃培 养箱中消化 1-2 分钟,然后在显微镜下观察细胞消化情况,若细胞大部分 变圆并脱落 ,迅速拿回操作台,轻敲几下培养 瓶后加少量培养基终止消 化。
3. 按 6-8ml/瓶补加培养基,轻轻打匀后吸出,在 1000RPM 条件下离心 4 分 钟,弃去上清液,补加 1-2mL 培养液后吹匀。
4. 将细胞悬液按 1:2 比例分到新的含 8ml 培养基的新皿中 或者瓶中。
3)细胞冻存:待细胞生长状态良好时,可进行细胞冻存。下面 T25 瓶为类;
1. 细胞冻存时,弃去培养基后,PBS 清洗一遍后加入 1ml 胰酶,细胞变圆 脱 落后,加入 1ml 含血清的培养基终止消化,可使用血球计数板计数。
2. 4 min 1000rpm 离心去掉上清。加 1ml 血清重悬细胞, 根据细胞数量加 入血 清和 DMSO,轻轻混匀,DMSO 终浓度为 10%,细胞密度不低于1x106/ml,每支冻 存管冻存 1ml 细胞悬液,注意冻 存管做好标识。
3. 将冻存管置于程序降温盒中,放入-80 度冰箱,2 个小时 以后转入液氮灌储存。记录冻存管位置以便下次拿取。
L5178Y TK+/- (clone 3.7.2C)细胞ATCC CRL-9518小鼠淋巴瘤细胞培养注意事项
1. 收到细胞后首先观察细胞瓶是否完好,培养液是否有漏液、浑浊等现象,若有上述 现 象发生请及 时和我们联系。2. 仔细阅读细胞说明书,了解细胞相关信息,如细胞形态、所用培养基、血清比例、 所 需细胞因子 等,确保细胞培养条件一致。若由于培养条件不一致而导致细胞出现问 题,责任由客户 自行承担。
3. 用 75%酒精擦拭细胞瓶表面,显微镜下观察细胞状态。因运输问题贴壁细 胞会有少量 从瓶 壁脱落,将细胞置于培养箱内静置培养 4~6 小时,再取出观察。此时多数细胞均 会贴 壁,若细胞仍不能贴壁请用台盼蓝 染色测定细胞活力,如果证实细胞活力正常, 请将细胞离心后用新鲜 培养基再次贴壁培养;如果染色结果显示细胞无活 力,请拍下 照片及时和我们联系,信息确认后我们为 您再免费寄送一次。
4. 静置细胞贴壁后,请将细胞瓶内的培养基倒出,留 6~8mL 维持细胞正常培 养,待细 胞汇 合度 80%左右时正常传代。
5. 请客户用相同条件的培养基用于细胞培养。培养瓶内多余的培养基可收集备用,细 胞 传代时可以 一定比例和客户自备的培养基混合,使细胞逐渐适应培养条件。
6. 建议客户收到细胞后前 3 天各拍几张细胞照片,记录细胞状态,便于和 Procell 技术 部 沟通交流。由于运输的原因,个别敏感细胞会出现不稳定的情况,请及时和我们联 系 ,告知细胞的具体情况,以便我们 的技术人员跟踪回访直至问题解决。
7.该细胞仅供科研使用。